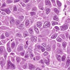

A 61-year-old male with a 3-month history of cough. Mass found in lung and excised. Click here to see the whole slide image.
Click here for the comparative pathology.
Your diagnosis is:
Stay up to date on recent advances in the multidisciplinary approach to cancer.